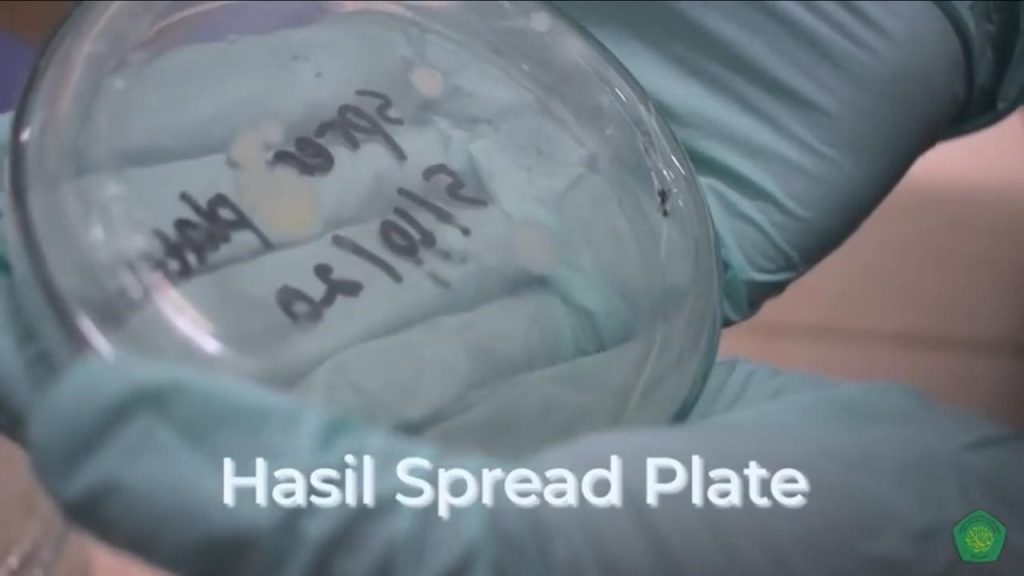
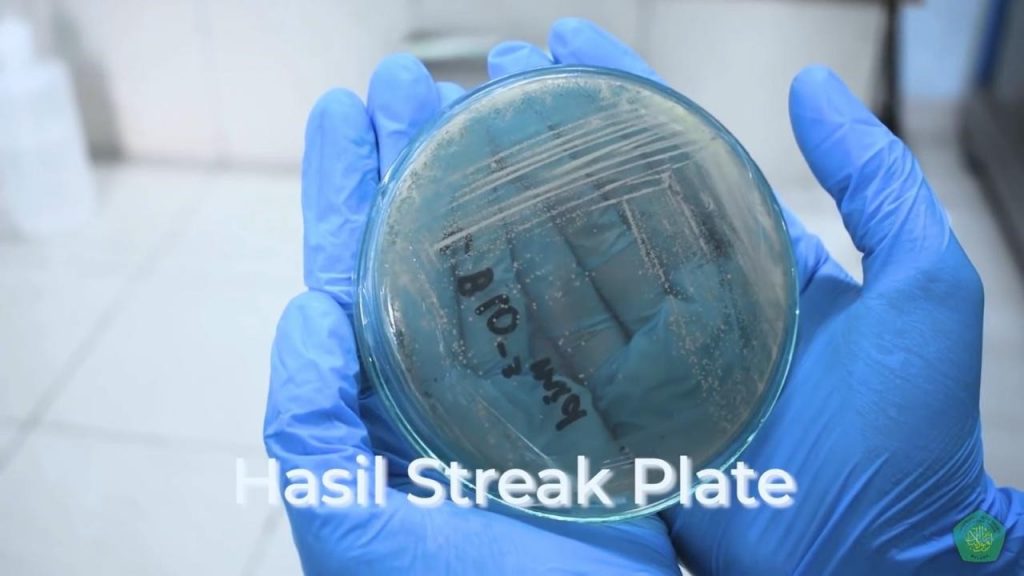
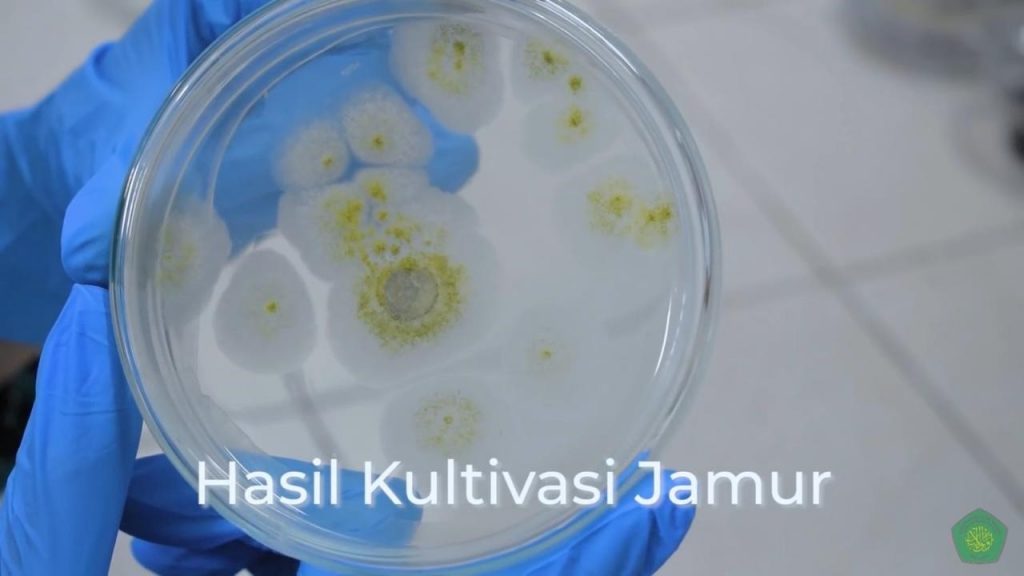
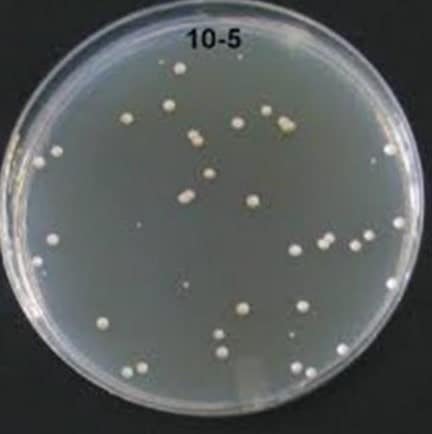

Daftar Isi
BAB I
PENDAHULUAN
1.1 Latar Belakang
Tidak hanya dipelajari karena sifatnya yang patogen. Aplikasi bioteknologi banyak menggunakan bantuan mikroorganisme. Manfaatnya dalam berbagai bidang ini menjadikan mikroba banyak dibiakkan. Akan tetapi, keberhasilan dalam proses menumbuhkan mikroba tidak hanya bergantung dalam proses pembuatan media saja, setelahnya masih ada beberapa proses yang harus dilakukan untuk memperoleh mikroba yang diinginkan.
Mikroba hampir dapat ditemukan pada semua tempat, oleh karena itu, dalam usaha untuk menumbuhkan mikroba yang diinginkan diperlukan pengetahuan yang cukup untuk bisa mengisolasi mikroba dari lingkungannya. Menurut Putri, Sukini dan Yadong (2017) Pada umumnya mikroba yang hidup di alam terdapat dalam bentuk populasi campuran. Sangat jarang mikroba di alam dijumpai sebagai spesies yang tunggal. Dengan demikian, agar mikroba tersebut dapat diidentifikasikan, sehingga mudah dipelajari sifat pertumbuhan, morfologis, dan fisiologis masing-masing mikroba maka langkah pertama yang harus dilakukan yaitu spesies tersebut dipisahkan dari organisme lain yang umum dijumpai dalam habitatnya, kemudian ditumbuhkan menjadi biakan murni yaitu suatu biakan yang terdiri dari sel-sel dari satu spesies.
Terdapat beberapa teknik yang perlu diperhatikan dalam menumbuhkan mikroba, mulai dari langkah-langkah dalam pengambilan sampel mikroba, cara-cara memindahkan mikroba secara aseptis, kemudian mikroba diisolasi dan ditanam dalam media hingga akhirnya mikroba dapat diidentifikasi melalui morfologinya. Teknik-teknik ini kemudian tidak lepas dari upaya untuk menghitung jumlah koloni mikroba yang tumbuh pada media sehingga didapatkan data biakkan yang lebih akurat. Biakan ini kemudian yang nantinya akan digunakan dalam identifikasi mikroba patogen maupun dimanfaatkan dalam pembuatan berbagai macam produk bioteknologi. Oleh karena itu, praktikum ini penting untuk dilakukan karena kesiapan dan pengetahuan dalam melakukan teknik-teknik tersebut menentukan berhasil atau tidaknya proses dalam menumbuhkan mikroba.
[inline_ads]
1.2 Rumusan Masalah
Rumusan masalah dalam praktikum ini adalah:
- Bagaimana langkah-langkah pengambilan sampel?
- Bagaimana cara-cara pemindahan mikroba secara aseptis?
- Bagaimana teknik-teknik isolasi dan penanaman mikroba?
- Bagaimana morfologi koloni mikroba pada media?
- Bagaimana metode penghitungan jumlah mikroba Total Plate Count?
1.3 Tujuan
Tujuan dilakukan praktikum ini adalah:
- Mempelajari langkah-langkah pengambilan sampel,
- Mempelajari cara-cara pemindahan mikroba secara aseptis,
- Mempelajari teknik-teknik isolasi dan penanaman mikroba,
- Mempelajari morfologi koloni mikroba pada media, dan
- Mengetahui metode penghitungan jumlah mikroba Total Plate Count.
1.4 Manfaat
Manfaat dilakukannya praktikum ini adalah:
- Menambah wawasan terkait langkah-langkah pengambilan sampel,
- Menambah wawasan terkait cara-cara pemindahan mikroba secara aseptis,
- Menambah wawasan terkait teknik-teknik isolasi dan penanaman mikroba,
- Menambah wawasan terkait morfologi koloni mikroba pada media, dan
- Menambah wawasan terkait metode penghitungan jumlah mikroba Total Plate Count.
[inline_ads]
BAB II
TINJAUAN PUSTAKA
2.1 Isolasi Mikroba
Proses isolasi mikroba adalah memisahkan mikroba satu dengan mikroba lain yang berasal dari campuran berbagai mikroba untuk dapat mempelajari sifat biakan, morfologi dan sifat mikroba lainnya (Puspitasari, Shovitri & Kuswytasari, 2012). Proses ini juga bertujuan untuk mendapatkan biakan murni (Putri, & Kusdiyanti, 2018).
Berbagai macam cara dalam mengisolasi mikroba menurut Putri, Sukini dan Yadong (2017) yaitu :
1. Metode isolasi pada medium cair
Dilakukan bila mikroorganisme tidak dapat tumbuh pada agar cawan (medium padat), tetapi hanya dapat tumbuh pada kultur cair. Metode ini juga perlu dilakukan pengenceran dengan beberapa serial pengenceran. Semakin tinggi pengenceran peluang untuk mendapatkan satu sel semakin besar.
2. Isolasi sel tunggal
Metode isolasi sel tunggal dilakukan untuk mengisolasi sel mikroorganisme berukuran besar yang tidak dapat diisolasi dengan metode agar cawan atau medium cair.
3. Isolasi pada agar cawan
Prinsip pada metode isolasi pada agar cawan adalah mengencerkan mikroorganisme sehingga diperoleh individu spesies yang dapat dipisahkan dari organisme lainnya.
4. Metode cawan gores (streak)
Metode ini Bertujuan untuk mengisolasi mikroorganisme dari campuran atau meremajakan kultur ke alam medium baru. Metode ini mempunyai dua keuntungan, yaitu menghemat bahan dan waktu.
[inline_ads]
2.2 Serial Dilution
Tujuan dari pengenceran bertingkat adalah mengurangi jumlah mikroba dalam cairan. Penentuan tingkat pengenceran tergantung kepada perkiraan jumlah mikroba yang ada pada sampel. Digunakan perbandingan 1:9 untuk sampel pengenceran pertama hingga selanjutnya sehingga didapat 1/10 sel mikroorganisme dari pengenceran sebelumnya. Setelah pengenceran pada tabung pertama selesai, 1 ml sampel dituang ke dalam tabung kedua menggunakan mikropipet, kemudian divortex dan menuang 1 ml sampel dari tabung kedua ke tabung ketiga (Tyas, Niniek & Solichin, 2018).
2.3 Kultivasi Mikroba
Kultivasi merupakan proses memperbanyak organisme yang dilakukan dengan menyediakan kondisi lingkungan yang cocok untuk organisme yang akan diperbanyak. Parasit, bakteri, dan virus umumnya perlu dikultivasi untuk studi lebih lanjut (Riedel et al., 2019). Macam-macam metode kultivasi mikroba menurut Riedel et al., (2019) yaitu:
1. Metode pour-plate
Metode pour-plate menggunakan suspensi sel encer yang dicampur dengan agar cair pada suhu 50°C yang kemudian dituang ke cawan petri. Ketika agar memadat, sel-selnya tersebut akan kesulitan bergerak dan tumbuh membentuk koloni. Jika suspensinya cukup encer, kemungkinan koloni yang muncul merupakan keturunan dari satu sel saja sangat tinggi. Metode pour-plate sering kali digunakan untuk menghitung jumlah mikroorganisme dalam suatu sampel campuran yang ditambahkan ke medium agar yang meleleh yang kemudian memadat. Proses ini membuat koloni menyebar secara merata pada medium tersebut (Sanders, 2012).
2. Metode streak-plate
Dalam metode ini, suspensi sel digoreskan pada permukaan agar pada proses penggoresan, semakin lama penggoresan akan semakin sedikit sel pada hasil goresannya. Cawan kemudian diinkubasi dan setiap koloni yang terisolasi dikeluarkan dan disuspensi kembali dalam media steril lalu hasil suspensinya digoreskan kembali pada agar. Metode streak-plate dirancang untuk mengisolasi kultur murni suatu bakteri dari suatu populasi campuran dengan metode pemisahan yang sederhana (Sanders, 2012).
[inline_ads]
3. Metode spread-plate
Suspensi mikroba encer dalam volume kecil yang mengandung sekitar 30-300 sel dipindahkan ke tengah cawan agar dan disebarkan secara merata pada permukaan agar dengan batang kaca steril. Sel yang tersebar akan tumbuh membentuk koloni yang terisolasi. Karena jumlah koloni harus sama dengan jumlah organisme yang dapat hidup dalam sampel, spread-plate dapat digunakan untuk menghitung populasi mikroba.
2.4 Purifikasi Mikroba
Purifikasi merupakan pemurnian atau memisahkan koloni bakteri agar hanya didapatkan bakteri yang murni (Pamaya et al., 2018). Dalam hal yang demikian ini dapat kita jadikan piaraan murni. Jika kita belum yakin bahwa koloni tunggal yang kita peroleh tersebut merupakan koloni yang murni, maka kita dapat mengulang pengenceran dengan menggunakan koloni ini sebagai sampel. Proses pemisahan/pemurnian dari mikroorganisme lain perlu dilakukan karena semua pekerjaan mikrobiologis, misalnya telaah dan identifikasi mikroorganisme, memerlukan suatu populasi yang hanya terdiri dari satu macam mikroorganisme saja Isolasi ke media padat (Putri,Sukini & Yadong, 2017).
2.5 Enumerasi Mikroba
Perhitungan jumlah bakteri merupakan salah satu cara yang dilakukan untuk bisa mengetahui berapa banyak koloni bakteri yang terdapat pada suatu media, baik itu koloni sel yang hidup maupun koloni sel bakteri yang mati. Metode yang digunakan adalah perhitungan secara langsung dan perhitungan secara tidak langsung. Perhitungan jumlah bakteri secara langsung digunakan untuk menentukan jumlah bakteri keseluruhan baik yang mati maupun yang hidup. Sedangkan perhitungan bakteri secara tidak langsung digunakan untuk menentukan jumlah bakteri yang hidup saja (Rosmania, & Yanti, 2020).
Penghitungan secara langsung dapat dilakukan secara mikroskopis yaitu dengan menghitung jumlah bakteri dalam satuan isi yang sangat kecil. Alat yang digunakan adalah PetroffHauser Chamber atau Haemocytometer. Ruang hitung terdiri dari 9 kotak besar dengan luas 1 mm². Satu kotak besar di tengah, dibagi menjadi 25 kotak sedang dengan panjang 0,2 mm. Satu kotak sedang dibagi lagi menjadi 16 kotak kecil. Dengan demikian satu kotak besar tersebut berisi 400 kotak kecil. Tebal dari ruang hitung ini adalah 0,1 mm (Wijaya, Utari & Yudianingsih, 2015).
[inline_ads]
Beberapa teknik dalam perhitungan tidak langsung diantaranya yaitu:
1. Metode Hitung Cawan
Prinsip dari metode hitungan cawan adalah menumbuhkan sel-sel mikroba yang masih hidup pada suatu atau beberapa media sehingga sel tersebut berkembang biak dan membentuk koloni-koloni yang dapat dilihat langsung dengan mata telanjang tanpa menggunakan mikroskop, dan koloni dapat dihitung menggunakan colony counter (Tyas, Niniek & Solichin, 2018). dalam suatu preparat biasanya berisi 30-300 koloni. Jumlah organisme yang terdapat dalam sampel asal dihitung dengan cara mengalikan jumlah koloni yang terbentuk dengan faktor pengenceran pada preparat bersangkutan. (Wijaya, Utari & Yudianingsih, 2015).
2. Metode Turbidimetri
Teknik ini sudah dipakai sebagai cara mengukur kekeruhan suspensi atas dasar penyerapan dan pemencaran cahaya yang dilintaskan, sehingga yang mengandung lebih dari 107-108 sel/ml, tampak lebih keruh oleh mata telanjang. Kelebihannya adalah dapat digunakan untuk isolasi dan identifikasi bakteri, bakteri yang dihitung adalah bakteri yang hidup. Sedangkan kekurangannya adalah perhitungannya kurang akurat karena ada kemungkinan beberapa sel bertumpuk, ada kemungkinan terjadi spreader, waktu yang dibutuhkan cukup lama, bahan yang digunakan relatif banyak (Putri,Sukini & Yadong, 2017).
BAB III
METODE PRAKTIKUM
3.1 Waktu dan Tempat
Praktikum Mikrobiologi Umum dengan judul “Teknik Isolasi, Penanaman (Kultivasi), Pemurnian (Purifikasi) Dan Penghitungan Jumlah (Enumerasi) Mikroba” ini dilaksanakan pada hari Senin, tanggal 23 November 2020 pada pukul 18.00 WIB sampai selesai. Praktikum dilaksanakan secara online di Jalan H.M. Thaib, Kabupaten Berau melalui media whatsapp.
[inline_ads]
3.2 Alat dan Bahan
3.2.1 Alat
Alat-alat yang digunakan dalam praktikum ini yaitu:
1. Isolasi bakteri dari tanah
Untuk mengisolasi bakteri dari tanah, alat-alat yang digunakan yaitu sepasang sarung tangan steril untuk melindungi sampel dari kontaminasi, satu buah plastik klip steril sebagai wadah sampel tanah, satu buah auger/gurdi untuk mengambil sampel tanah dan timbangan analitik untuk menimbang sampel tanah.
2. Teknik Sterilisasi Serial Dilution
Alat-alat yang digunakan untuk sterilisasi serial dilution yaitu tujuh buah tabung reaksi sebagai wadah suspensi, vortex untuk menghomogenkan suspensi, satu buah mikro pipet untuk memindahkan suspensi ke tabung reaksi yang lain.
3. Teknik Pour-Plate
Alat-alat yang digunakan untuk teknik pour-plate yaitu satu buah mikro pipet untuk mengambil suspensi dari tabung reaksi, satu buah cawan petri sebagai wadah suspensi dan media, serta inkubator untuk menginkubasi cawan petri yang telah berisi media dan suspensi.
4. Teknik Spread-Plate
Alat-alat yang digunakan dalam teknik spread-plate yaitu mikro pipet untuk memindahkan suspensi ke media di cawan petri, satu buah spreader/batang bengkok untuk meratakan kultur bakteri pada permukaan media, serta inkubator untuk menginkubasi cawan petri.
5. Teknik Streak-Plate
Alat-alat yang digunakan dalam teknik streak-plate adalah satu buah jarum ose untuk mengambil kultur murni bakteri, spidol untuk menandai kuadran pada cawan petri, dan inkubator untuk menginkubasi cawan petri.
[inline_ads]
6. Teknik Isolasi Bakteri Kulit
Alat-alat yang digunakan dalam teknik isolasi bakteri kulit yaitu cotton swab untuk mengambil sampel bakteri dari kulit dan inkubator untuk menginkubasi kultur.
7. Teknik Kultivasi Jamur
Alat-alat yang digunakan dalam teknik kultivasi jamur yaitu tip biru steril untuk memotong koloni jamur beserta medianya, kertas dan spidol untuk melabeli isolat, serta inkubator untuk menginkubasi isolat.
3.2.2 Bahan
Bahan-bahan yang digunakan dalam praktikum ini yaitu:
1. Isolasi bakteri dari tanah
Bahan-bahan yang digunakan dalam isolasi bakteri tanah yaitu tanah yang akan digunakan sebagai sampel dalam praktikum.
2. Teknik Sterilisasi Serial Dilution
Bahan-bahan yang digunakan dalam teknik sterilisasi serial dilution adalah NaCl fisiologis untuk mengencerkan sampel yang mengandung mikroba.
3. Teknik Pour-Plate
Bahan-bahan yang digunakan dalam teknik pour-plate yaitu medium NA sebagai media pertumbuhan bakteri yang terlebih dahulu telah ditambahkan dengan anti fungi untuk mencegah pertumbuhan jamur pada media bakteri.
[inline_ads]
4. Teknik Spread-Plate
Bahan-bahan yang digunakan dalam teknik spread-plate yaitu medium NA sebagai media pertumbuhan bakteri yang terlebih dahulu telah ditambahkan dengan anti fungi untuk mencegah pertumbuhan jamur pada media bakteri.
5. Teknik Streak-Plate
Bahan-bahan yang digunakan dalam teknik streak-plate yaitu medium NA sebagai media pertumbuhan bakteri yang terlebih dahulu telah ditambahkan dengan anti fungi untuk mencegah pertumbuhan jamur pada media bakteri.
6. Teknik Isolasi Bakteri Kulit
Bahan-bahan yang digunakan dalam teknik isolasi bakteri kulit yaitu NaCl fisiologis sebagai larutan pengencer dan medium NA sebagai media pertumbuhan bakteri yang terlebih dahulu telah ditambahkan dengan anti fungi untuk mencegah pertumbuhan jamur pada media bakteri.
7. Teknik Kultivasi Jamur
Bahan-bahan yang digunakan dalam teknik kultivasi jamur yaitu koloni bakteri beserta media untuk dipindahkan ke media yang baru.
3.3 Langkah Kerja
3.3.1 Teknik Isolasi Bakteri Tanah
Langkah-langkah dalam mengisolasi bakteri tanah yaitu diambil sampel tanah kemudian dimasukkan ke dalam plastik. Setelah itu, ditimbang sampel tanah menggunakan timbangan analitik sebanyak 1 gram untuk selanjutnya diisolasi.
[inline_ads]
3.3.2 Teknik Sterilisasi Serial Dilution
Langkah-langkah dalam melakukan pengenceran bertingkat yaitu diisi sebanyak tujuh tabung reaksi dengan NaCl fisiologis 9 ml. sampel tanah yang telah ditimbang dimasukkan ke dalam tabung reaksi pengenceran pertama secara aseptis. Kemudian, homogenkan sampel menggunakan vortex. Diambil 1 ml suspensi tabung 10-1 dengan mikro pipet kemudian dipindahkan ke tabung reaksi 10-2 secara aseptis. Dilanjutkan pemindahan suspensi hingga tabung reaksi terakhir dengan cara yang sama.
3.3.3 Teknik Pour-Plate
Langkah-langkah dalam melakukan teknik pour-plate yaitu dimasukkan 1 ml suspensi tabung 10-7 ke dalam cawan petri kosong yang steril secara aseptis. Dituangkan media agar hangat bersuhu 45℃ lalu kemudian ditutup. Dihomogenkan campuran media dan suspensi dengan cara diputar perlahan membentuk angka delapan. Setelah agar memadat, ditutup cawan petri kemudian diinkubasi selama 24 jam.
3.3.4 Teknik Spread-Plate
Langkah-langkah dalam melakukan teknik spread-plate yaitu dipindahkan 0,1 ml suspensi bakteri secara aseptis ke permukaan media yang telah memadat dalam cawan petri menggunakan mikro pipet. Disterilisasi spreader/batang bengkok dengan cara dicelupkan dalam alkohol 70%. Dibakar spreader dengan cara dilewatkan di atas api dan dibiarkan spreader dingin. Disebarkan kultur bakteri dengan spreader secara merata dan dibiarkan sampai permukaan agar mengering. Setelah permukaan agar mengering, diinkubasi cawan petri secara terbalik selama 24 jam di dalam inkubator.
3.3.5 Teknik Streak-Plate
Langkah-langkah dalam melakukan teknik streak-plate yaitu ditandai bagian luar bawah cawan petri dengan menggunakan spidol menjadi empat bagian. Kemudian, diinokulasi daerah satu dengan streak zig-zag. Dipanaskan jarum ose dan ditunggu hingga dingin, kemudian dilanjutkan streak ke daerah dua. Dilakukan prosedur yang sama pada daerah tiga dan empat.
[inline_ads]
3.3.6 Teknik Isolasi Bakteri Kulit
Langkah-langkah dalam melakukan teknik isolasi bakteri kulit yaitu dibasahi cotton swab ke dalam NaCl fisiologis, dioleskan cotton swab ke permukaan kulit, lalu digoreskan pada permukaan media NA padat dengan metode goresan sinambung. Selanjutnya, diinkubasi selama 24 jam dalam inkubator.
3.3.7 Teknik Kultivasi Jamur
Langkah-langkah dalam melakukan teknik kultivasi jamur yaitu dipotong koloni jamur beserta medianya menggunakan tip biru steril secara aseptis, dipindahkan koloni jamur ke media baru dengan posisi koloni jamur bersentuhan dengan media baru. Sebelum diinkubasi, terlebih dahulu diberi isolat label nama isolat, pemilik, dan tanggal inkubasi. Selanjutnya, diinkubasi pada suhu ruang selama lima hingga tujuh hari dengan posisi media cawan petri berada di atas.
BAB IV
HASIL DAN PEMBAHASAN
4.1 Isolasi dan Kultivasi Bakteri Tanah
Hasil yang diperoleh dari isolasi dan kultivasi bakteri tanah menggunakan metode pour-plate dan spread-plate yaitu:

Berdasarkan praktikum yang telah dilakukan, setelah melalui proses inkubasi selama 24 jam, diperoleh hasil pertumbuhan bakteri yang ditunjukkan pada gambar di atas. Metode yang digunakan dalam teknik kultivasi bakteri tanah dalam praktikum ini yaitu metode pour-plate dan metode spread-plate. Sebelum melakukan kultivasi, terlebih dahulu dilakukan pengambilan sampel bakteri dari tanah dan diambil sebanyak 1 gram untuk diisolasi. Setelahnya, dilakukan penyaringan bertingkat untuk mengurangi jumlah bakteri yang tersuspensi ke dalam cairan, suspensi yang digunakan dalam praktikum ini yaitu suspensi pada tabung pengenceran 10-7. Setelah diencerkan kemudian dilakukan penanaman menggunakan teknik pour-plate dan spread-plate.
[inline_ads]
Pada teknik pour-plate, suspensi dituang terlebih dahulu pada cawan petri dan dilanjutkan oleh penuangan media agar yang belum memadat, oleh karena itu, bakteri yang tumbuh merupakan bakteri yang membutuhkan oksigen pada permukaan atas media dan juga bakteri yang membutuhkan sedikit oksigen yang tumbuh di dalam agar seperti pada gambar di atas. Pernyataan ini didukung oleh teknik pour-plate memerlukan agar yang belum padat (>45℃) untuk dituang bersama suspensi bakteri ke dalam cawan petri lalu kemudian dihomogenkan dan dibiarkan memadat. Hal ini akan sel bakteri tidak hanya pada permukaan saja melainkan terendam agar (di sel yang tumbuh di permukaan agar yang kaya oksigen dan ada yang tumbuh di dalam agar yang tidak begitu banyak mengandung oksigen (Putri, Sukini &Yadong 2017). Berbeda halnya dengan teknik pour-plate, pada teknik spread-plate, suspensi dituang di atas media agar yang sudah memadat kemudian disebar menggunakan spreader sehingga bakteri akan tumbuh yaitu bakteri yang membutuhkan oksigen pada permukaan atas media seperti pada gambar di atas.
Hal ini didukung oleh pernyataan spread-plate adalah teknik isolasi mikroba dengan cara menyebarkan suspensi bakteri pada permukaan media yang akan digunakan. Untuk memperoleh kultur murni, adapun prosedur kerja yang dapat dilakukan adalah sebagai berikut: Ambil suspensi cair sebanyak 0,1 ml dengan pipet ukur kemudian teteskan di atas permukaan agar yang telah memadat. Batang L atau batang drugal diambil kemudian disemprot alkohol dan dibakar di atas api bunsen beberapa saat, kemudian didinginkan dan ditunggu beberapa detik. Kemudian disebarkan dengan menggosokkannya pada permukaan agar supaya tetesan suspensi merata, penyebaran akan lebih efektif bila cawan ikut diputar. Hal yang perlu diingat bahwa batang L yang terlalu panas dapat menyebabkan sel-sel mikroorganisme dapat mati karena panas (Putri, Sukini, &Yadong 2017).
4.2 Purifikasi Bakteri Tanah
Hasil yang diperoleh dari purifikasi bakteri tanah yaitu:
Berdasarkan pada praktikum yang telah dilakukan terkait dengan purifikasi bakteri tanah, setelah melalui proses inkubasi selama 24 jam didapati hasil pertumbuhan bakteri seperti pada gambar di atas. Pada teknik pemurnian (purifikasi) ini teknik yang digunakan yaitu teknik streak-plate. Teknik penanaman mikroba dengan goresan ini bertujuan untuk mengisolasi mikroorganisme dari campurannya agar didapatkan koloni terpisah yang merupakan biakan murni. Hasil pertumbuhan bakteri pada teknik pour-plate sebelumnya diambil untuk diinokulasikan menggunakan jarum ose yang terlebih dahulu di sterilkan dengan dilewatkan pada api bunsen. Pada praktikum ini, teknik goresan yang digunakan yaitu goresan kuadran sehingga daerah pada cawan petri dibagi menjadi empat bagian. Penggoresan zig-zag pada setiap kuadran harus dilakukan secara aseptis dekat dengan api bunsen dan lewatkan jarum ose terlebih dahulu sebelum melakukan penggoresan pada kuadran yang lain.
[inline_ads]
Pernyataan ini didukung oleh Hampir sama dengan goresan T, namun berpola goresan yang berbeda yaitu dibagi empat, daerah 1 merupakan goresan awal, sehingga masih mengandung mikroorganisme, goresan selanjutnya dipotong disilangkan dari goresan pertama jumlah semakin sedikit dan akhirnya terpisah berbeda yaitu dibagi empat, daerah 1 merupakan goresan awal, sehingga masih mengandung mikroorganisme, goresan selanjutnya dipotong disilangkan dari goresan pertama jumlah semakin sedikit dan akhirnya terpisah-pisah menjadi koloni tunggal (Putri, Sukini &Yadong 2017).
Cawan petri yang berisi media padat agar disiapkan, kemudian 1 koloni dominan dari biakan diambil dengan jarum ose steril berukuran 2 mm. jarum ose digoreskan pada media padat secara hati-hati dengan cara menggerakkan ujung ose ke arah sisi kanan beberapa kali. Ujung ose dibakar dan didinginkan kembali dan cawan diputar 90˚, lalu sentuh ujung ose pada area 1 dan digoreskan dengan menggerakkan ujung ose menyilang menuju area 2. Cara yang sama pun dilakukan untuk area 3. Dengan tanpa bakar ose, cawan diputar 90˚ lalu digoreskan dengan cara yang sama ke area 4. Cawan petri kemudian diinkubasi 24 jam (Sari, Abrar, & Merint, 2013).
4.3 Isolasi Bakteri Kulit
Hasil yang diperoleh dari isolasi bakteri kulit yaitu:

Berdasarkan praktikum yang telah dilakukan pada isolasi bakteri kulit, setelah dilakukan inkubasi selama 24 jam, didapatkan hasil pertumbuhan bakteri seperti pada gambar di atas. Dalam isolasi bakteri kulit, terlebih dahulu dilakukan pengambilan sampel pada kulit menggunakan cotton swab yang telah dicelupkan pada larutan NaCl fisiologis. Setelah sampel bakteri pada permukaan kulit tangan diperoleh, lalu cotton swab digoreskan di atas media NA padat dengan metode goresan sinambung.
Pernyataan ini didukung oleh metode swab menggunakan cotton bud steril pada sampel yang memiliki permukaan luas dan pada umumnya sulit dipindahkan atau sesuatu pada benda tersebut. Contohnya adalah Kulit manusia, meja, batu, batang kayu dll. Caranya dengan mengusapkan cotton bud memutar sehingga seluruh permukaan kapas dari cotton bud kontak dengan permukaan sampel. Swab akan lebih baik jika cotton bud dicelupkan terlebih dahulu ke dalam larutan atraktan (Putri, Sukini, & Yadong, 2017).
[inline_ads]
4.4 Kultivasi Jamur
Hasil yang diperoleh dari kultivasi jamur yaitu:
Berdasarkan pada praktikum yang telah dilakukan terkait kultivasi jamur, diperoleh hasil pertumbuhan jamur seperti pada gambar di atas. Sebelum jamur ditanam pada media baru, terlebih dahulu ambil sampel dengan cara memotong koloni jamur dan medianya menggunakan tip biru steril secara aseptis pada jamur lain yang sudah ditumbuhkan. Lalu setelahnya dilakukan inkubasi selama lima hingga tujuh hari dengan posisi media cawan petri berada di atas.
Pernyataan ini didukung oleh ambil sampel jamur dengan jarum ose yang sudah disterilkan dengan dipanaskan pada spiritus hingga merah, kemudian pindahkan ke dalam PDA miring dengan menggores menggunakan metode zig-zag agar tetap steril. Penyimpanan cawan dilakukan dengan meletakkan secara terbalik, yaitu permukaan medium menghadap ke bawah untuk menghindari tetesnya air yang mungkin akan melekat pada dinding dalam pada tutup cawan (Putri, Sukini &Yadong 2017).
[inline_ads]
4.5 Diskusi
1. Mengapa pada proses isolasi perlu dilakukan proses pengenceran dari sampel padat/cair?
Pada proses isolasi, perlu dilakukan proses pengenceran yang bertujuan untuk memperkecil atau mengurangi jumlah mikroba yang tersuspensi dalam cairan.
2. Apakah perbedaan prinsip dan cara kerja metode spread-plate dan pour-plate?
Perbedaan prinsip dan cara kerja pada metode spread-plate dan pour-plate yaitu teknik spread-plate merupakan teknik isolasi mikroba dengan cara menginokulasi kultur mikroba secara pulasan/sebaran di permukaan media agar yang telah memadat. metode spread-plate bertujuan untuk menumbuhkan bakteri pada permukaan media. Sedangkan metode pour-plate merupakan teknik isolasi mikroba dengan cara menuang agar yang belum padat (>45℃) bersama dengan suspensi bakteri ke dalam cawan petri lalu kemudian dihomogenkan dan dibiarkan memadat. Sehingga, tujuan dari teknik ini yaitu untuk menumbuhkan bakteri yang membutuhkan oksigen pada permukaan media dan juga bakteri yang hanya membutuhkan sedikit oksigen yang tumbuh di dalam media.
3. Tuliskan dalam tabel morfologi koloni yang berhasil diisolasi!
Kode Isolat | Karakteristik Morfologi | |||
Elevasi | Margin | Pigmentasi | Bentuk Koloni | |
Pour plate | Flat | Smooth | Non-pigmented | Round |
Spread plate | Flat | Smooth | Non-pigmented | Round |
Streak plate (Kuadran) | Drop-Like | Smooth | Non-pigmented | Round |
Streak plate (sinambung) | Drop-Like | Smooth | Non-pigmented | Round |
Kultivasi jamur | Hilly | Irregular | Pigmented | L-form |
4. Apa perbedaan antara morfologi koloni bakteri dengan fungi pada media agar?
Perbedaan antara morfologi koloni bakteri dan fungi pada media agar yaitu, pada koloni bakteri terlihat berbentuk bulat (round) dengan tepi yang licin (smooth) memiliki elevasi yang datar (flat), berwarna putih (non-pigmented), keruh dan suram dengan ukuran diameter yang tidak terlalu besar sedangkan pada fungi koloni terlihat membentuk L (L-form) yang memiliki tepi tidak rata (irregular), memiliki elevasi yang berbukit-bukit (hilly), berwarna kuning (pigmented) seperti serbuk dengan satu lingkaran besar di tengahnya dan dikelilingi oleh gumpalan seperti kapas berwarna putih dengan diameter lingkaran yang lebih besar daripada lingkaran koloni bakteri.
5. Hitunglah jumlah koloni bakteri pada cawan petri berikut menggunakan metode TPC!

\begin{aligned} Jumlah\space koloni &=258\\ FP&=10^{-4}\\ TPC (cfu/mL)&=Jumlah\space koloni \times (1/FP)\\ &=258\times 1/10^{-4}\\ &=258\times 10^4\\ &=2,58 \times 10^6\\ &=2.580.000 \space cfu/mL \end{aligned}
\begin{aligned} Jumlah\space koloni &=39\\ FP&=10^{-5}\\ TPC (cfu/mL)&=Jumlah\space koloni \times (1/FP)\\ &=39\times 1/10^{-5}\\ &=39\times 10^5\\ &=3,9 \times 10^6\\ &=3.900.000 \space cfu/mL \end{aligned}
[inline_ads]
BAB V
PENUTUP
5.1 Kesimpulan
Pengambilan sampel dalam praktikum ini meliputi teknik pengambilan sampel pada mikroba tanah dan pengambilan sampel mikroba pada kulit. Pengambilan sampel bakteri tanah dilakukan secara aseptis menggunakan sarung tangan, auger/gurdi, plastik klip steril serta timbangan analitik untuk mengambil sampel bakteri tanah sebanyak 1 gram. Sedangkan pada mikroba kulit dilakukan teknik swab menggunakan cotton swab yang dicelupkan pada larutan NaCl fisiologis.
Dalam melakukan pemindahan mikroba, perlu dipastikan bahwa teknik yang digunakan merupakan teknik aseptis sehingga mencegah kontaminasi pada kultur. Teknik aseptis dapat dilakukan dengan menggunakan api bunsen. Alat-alat seperti jarum ose dan spreader terlebih dahulu dilewatkan pada api sebelum digunakan, saat melakukan pemindahan cawan petri juga harus selalu dekat dengan api.
Teknik isolasi dan penanaman mikroba dapat dilakukan melalui metode pour-plate, spread-plate maupun streak-plate setelah dilakukan pengenceran bertingkat. Pada metode pour-plate akan dihasilkan mikroba yang tumbuh pada permukaan atas media dan di dalam media, pada metode spread-plate akan dihasilkan mikroba yang butuh oksigen sehingga tumbuh pada bagian permukaan atas. Sedangkan pada metode streak-plate akan ditemukan mikroba koloni tunggal yang merupakan biakan tunggal.
Perbedaan morfologi koloni paling jelas terlihat pada kultur bakteri dan jamur, pada metode spread-plate, pour-plate dan streak-plate ditemukan bakteri yang berwarna putih keruh (non-pigmented) dan berbentuk bulat (round). Pada bakteri tangan ditemukan mikroba berbentuk bulat (round) dan jernih (non-pigmented). Sedangkan pada kultivasi jamur ditemukan jamur yang berwarna kuning (pigmented), berbentuk bulat, tepi yang tidak rata dan dikelilingi oleh gumpalan seperti kapas yang berwarna putih. Perhitungan mikroba dilakukan melalui teknik hitung cawan/TPC Prinsip metode hitung cawan adalah jika sel mikroba yang masih hidup ditumbuhkan pada media agar, maka sel mikroba itu akan berbiak membentuk koloni yang dapat dilihat dan dihitung dengan mata telanjang
5.2 Saran
Pastikan bahwa setiap tahapan dilakukan secara aseptis agar menghindari terjadinya kontaminasi dari zat-zat yang tidak diinginkan.
[inline_ads]
Daftar Pustaka
Pamaya, D., Muchlissin, S. I., Maharani, E. T. W., Darmawati, S., & Ethica, S. N. (2018). Isolasi bakteri penghasil enzim protease bacillus amyloliquefaciens irod2 pada oncom merah pasca fermentasi 48 jam. Seminar Nasional Pendidikan Sains dan Teknologi (pp. 40-46). Unimus Press.
Puspitasari, F.D., Shovitri, M., & Kuswytasari, N.D. (2012). Isolasi dan karakterisasi bakteri aerob proteolitik dari tangki septik. Jurnal Sains Dan Seni ITS, 1(1).
Putri, A. L. O., & Kusdiyanti, E. (2018). Isolasi dan identifikasi bakteri asam laktat dari pangan fermentasi berbasis ikan (Inasua) yang diperjualbelikan di Maluku-Indonesia. Jurnal Biologi Tropika, 1(2).
Putri, M. H., Sukini, & Yadong. (2017). Mikrobiologi. Jakarta: Kementrian Kesehatan Republik Indonesia.
Riedel, S., Morse, S., Mietzner, T., & Miller, S. (2019). Jawetz, Melnick & Adelberg’s medical microbiology. New York City: Mc-Graw Hill.
Rosmania, & Yanti, F. (2020). Perhitungan jumlah bakteri di laboratorium mikrobiologi menggunakan pengembangan metode spektrofotometri. Jurnal Penelitian Sains, 22(2).
Sanders E. R. (2012). Aseptic laboratory techniques: plating methods. Journal of Visualized Experiments, (63).
Sari, M. L., Abrar, A., & Merint. (2013). Isolasi dan karakterisasi bakteri asam laktat pada usus ayam broiler. Agripet, 13(1).
Tyas, D. E., Widyorini, N., & Solichin, A. (2018). Perbedaan jumlah bakteri dalam sedimen pada kawasan bermangrove dan tidak bermangrove di perairan desa Bedono, Demak. Journal Of Maquares, 7(2).
Wijaya, R. C., Utari, E. L., & Yudianingsih. (2015). Perancangan alat penghitung bakteri. Jurnal Teknologi Informasi, 10(29).